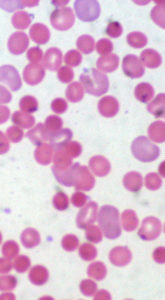
Top 9 Side Effects Of Turmeric & Curcumin Supplements

Top 9 Side Effects Of Turmeric & Curcumin Supplements

It’s already clear that turmeric brings a lot of benefits to our body. But is it all positive? Can’t it cause any harm, even in higher doses?
Today it’s time to take a look at the negative side – because there is one.
So what are the side effects of turmeric & curcumin supplements?
- How can they hurt you, and it what doses?
- And most importantly, are they really so harmless?
- Or they’re rather a blessing in disguise?
It’s time to dig deep into the facts and find out the truth about turmeric and curcumin supplements.
1. Digestive Problems
 Turmeric and curcumin are known for their gastroprotective effects.
Turmeric and curcumin are known for their gastroprotective effects.
Many patients take these herbs in order to protect their stomach from the effects of painkillers or NSAIDs.
- So how can they produce digestive problems as a side effect?
- Why are they said to protect the stomach if they don’t?
The reason why: Well, here is the explanation.
Turmeric and curcumin supplements don’t affect the stomach – but they can worsen an affection called gastroesophageal reflux disease.
This condition doesn’t affect the stomach itself, but rather the esophagus.
And though it usually doesn’t have a pathological cause, it can be very annoying.
So turmeric and curcumin don’t produce any damage the stomach. After all, they are meant to protect it.
But if gastroesophageal reflux condition is already present – these supplements may worsen it.
2. Kidney Stones
The title may be a bit deceiving here. Turmeric and curcumin don’t cause kidney stones themselves, that would be absurd.
But they can increase the risk – especially in a person who had this problem in the past.
The reason why: Turmeric contains a substance called oxalate.
Once this oxalate gets inside our body, it binds to calcium molecules and they form calcium oxalates. If you ever had kidney stones, you know this name so well.
Calcium oxalates are usually the structures that produce kidney stones:
- They are harder to eliminate
- So they tend to accumulate in our kidneys
- That’s how they form the so-called “stones”
Now, don’t imagine that consuming turmeric or taking it as supplements will give you kidney stones. As I said before, it can only increase the risk.
And unless you have had problems in the past or you know you’re inclined to kindey affections, you shouldn’t worry too much.
3. Nausea
 Not everyone tolerates every single drug, you probably know that.
Not everyone tolerates every single drug, you probably know that.
In fact, nausea is one of the most common side effects of drugs in general – and turmeric supplements make no exception.
The reason why: In some cases, this herb can produce mild nausea and diarheea.
I said before that turmeric can aggravate a gastroesophageal reflux disease.
This happens because turmeric tends to irritate the esophagus and part of the stomach. That’s why nausea appears as well.
But don’t get too scared. Nausea from turmeric usually appears if you take:
- high doses (over 4 grams per day)
- for at least a few months
So if you’ve been taking your herbal supplement for a while and you start getting nausea, don’t panic.
It may be just because of the pills, so stop the treatment for a few days and see how you’re feeling.
4. Allergies
You see this side effect on almost every drug’s label.
But in reality – there are quite a few people who really develop allergy as a side effect. However, it also exists in turmeric’s field.
The reason why: Allergic reactions usually come as:
- an urticaria
- a dermatitis
Now – these are both pretty minor affections. Rashes aren’t very common, or at least there weren’t many cases reported.
What’s interesting is that there is a certain category of people allergic to turmeric supplements:
- the ones allergic to ginger
- or allergic to yellow food coloring
Ginger belongs to the same family as turmeric, so the connection makes sense.
Therefore, if you know your body doesn’t tolerate these things very well – it’s better to stay away from turmeric. It may not cause you any harm, but it’s better to stay safe.
5. Bleeding Problems
 Turmeric and curcumin have never been friends with blood thinning drugs.
Turmeric and curcumin have never been friends with blood thinning drugs.
The reason why: In fact, some studies showed that curcumin slows down blood clotting.
At first sight, this may seem very useful – taking turmeric can help with your varicosity.
But surprisingly, turmeric supplements are forbidden together with blood thinning medicines.
On the other hand, if you suffer from bleeding conditions like haemophilia – turmeric and curcumin supplements are also a big no:
- They decrease blood clotting
- So they can increase the risks of bleeding
And this is enough to kill someone with a bleeding affection.
6. Iron Deficiency
If there’s someone most people don’t know about turmeric – it’s that it can cause a certain level of anemia.
If there’s someone most people don’t know about turmeric – it’s that it can cause a certain level of anemia.
This doesn’t happen everyday, but there were enough cases reported in the past.
Studies showed that the substances from turmeric powder can bind to iron molecules.
Where can we find iron in our bodies? Mostly in the red cells, the ones that carry the oxygen molecules.
The reason why: Once turmeric’s compounds bind to the iron molecules, our body can’t absorb enough iron from the foods we eat.
So that’s how iron deficiency appears. And the immediate consequence of this is anemia, one of the most common problems in these days.
The bad news is that:
- sometimes it’s so hard to find out what’s causing this anemia
Who would think that a harmless turmeric supplement can produce such a massive effect?
Probably no one, that’s why it’s so important to let your doctor know about all your medication – even herbal remedies that are apparently harmless.
Iron deficiency caused by turmeric supplements it pretty rare, but it does exist.
7. Gallbladder Problems
Just like they can cause kidney stones, turmeric supplements can also cause gallbladder issues.
The reason why: As I told you before, turmeric powder contains a substance called oxalate.
Once this oxalate binds to calcium molecules, it can produce kindey stones. That’s the classic scenario.
The other possible scenario is not so common – but it can happen if you have a history of gallbladder problems:
- The calcium oxalates can add up in your gallbladder instead
- So they cause stones there
Once again, that’s not something that happens daily, but you have to be aware of this risk if you start taking turmeric supplements.
It’s been scientifically proved that turmeric consumption increases the amount of oxalates from our blood. So make sure you are free of any possible problems before starting a treatment with curcumin and turmeric remedies.
8. Contractions
Though there isn’t any real evidence that it would be harmful – turmeric is forbidden in pregnancy and breastfeeding.
In fact, scientists say that consuming turmeric as a spice during pregnancy is totally harmless.
However, there’s a reason why the supplements aren’t allowed in pregnancy.
The reason why: In a higher dose, turmeric was proved to stimulate uterine contractions.
During pregnancy, this would be extremely dangerous because it would mean risking the baby’s life.
So if you experience joint pain at that time, it’s best to talk to your doctor instead of taking any supplement.
When it comes to breastfeeding – there aren’t many reports or information. Scientists don’t know yet if turmeric would pass through breast milk, and this means it’s better to stay away from it.
9. Headaches
 This is another very common symptom of most drugs. So surprisingly or not, turmeric is also on the list.
This is another very common symptom of most drugs. So surprisingly or not, turmeric is also on the list.
The reason why: Higher doses of turmeric and curcumin can lower the blood pressure. And the first symptoms that indicate a lower blood pressure are:
- headaches
- dizziness
Normally, no one would think it’s the herbal supplement behind all this.
But if it’s taken in a higher dose for a longer period (like a few months), turmeric can produce this effect.
However, don’t worry about consuming too much turmeric as a spice.
Even if you’re using it daily, it’s not enough to cause you any side effect, except maybe for a small allergy. It’s only the supplements that can lower the blood pressure or produce any other side effect.
So What Side Effect Have You Experienced?
If you’ve never tried turmeric before and you’re thinking about starting a treatment, I hope this post didn’t scare you too much. This wasn’t the point, that’s for sure.
Don’t worry, you won’t get any side effect overnight or in the first week.
You should take a pretty high dose for a few months to see the side effects. Something above 4 grams per day.
Otherwise, you could at most get a small allergy, but even that is very unlikely.
Turmeric can produce:
- kidney or gallbladder stones
- digestive problems
- nausea
But these are effects that appear very rarely. In fact, it is quite a safe herb, so don’t get discouraged by these possible side effects.
So which of the side effects of turmeric & curcumin supplements have you experienced? Let me know your answer in a comment and I will reach out to you.





Hey. I took curcumin pills when I was young, maybe 10 years ago. My doctor recommended me a certain supplement for general wellness, I can’t tell the name but I remember it was based on curcumin.
Well, everytime I took it I was feeling really bad for a couple of minutes, I had nausea all the time and I was even vomiting sometimes. Obviously, I gave it up very soon and never wanted to hear about it again.
I found your blog while looking for joint pain solutions, and that’s how I understood all the story. I had those symptoms because I was taking the pills randomly, sometimes after eating but usually before the meals.
So do you think that if I took them after eating that nausea wouldn’t come back?
Hi Mary, you’re totally right. Sometimes doctors don’t tell you when to take the pills, and in some cases it’s not even written on the label. And for curcumin pills, that really makes a difference.
Curcumin is great for joint pain, so I’m sure it would solve your problems. Try taking the supplement only after you eat consistently and you shouldn’t experience any nausea again.
Hello. I’m a 32 year old woman with rheumatoid arthritis and I’m 3 months pregnant. My symptoms weren’t very severe before, so I could keep the pain under control with different products.
Turmeric pills were among my favorites, as they would take away all my pain. I guess I was a pretty lucky RA patient.
Well, since I discovered I was pregnant I stopped the pills, but obviously the pain came back. From what I read in your post, you don’t recommend taking turmeric during pregnancy because of contractions. What should I take then? I didn’t get an appointment to my rheumatologist yet.
Hi Kira. Joint pain can appear even in healthy women during preganancy. As you already have RA, it’s quite clear that your pain will come back after quitting the pills.
As your pregnancy is in the first trimester, it’s extremely important to stay away from any supplement (unless your doctor prescribed it to you). Even turmeric supplements aren’t recommended. It’s not just because of contractions. Your baby’s body develops most in the first 3 months, so any medicine you take randomly is really dangerous for him. So you did very well quitting the pills you were taking.
I cannot recommend you any alternative supplement, because they are all dangerous in pregnancy. You can either ask your rheumatologist, or your OB, in case you can’t reach the first. They will probably prescribe you a certain medicine, which I can’t.
Let me know how things go.
Hey Heather, thank you for clarifying things out for me. I’ve been taking turmeric pills for a very long while, to treat the inflammation caused by a leg tendinitis. A few years back, I would work out a lot so I got some tendon problems as a consequence. I heard about turmeric and I’ve been taking it ever since. I saw that it healed my tendons so I kind of do it as a prevention method.
Do you think that on the long term I could get kidney or gallbladder stones? That’s what worries me the most from that list. I’m taking turmeric pills for about 2 years now, with very little breaks. Do you think I should give it up now? But if I do, won’t my tendon problems come back?
Thank you and sorry if it’s a silly question.
Hi Kaylene, it’s not a silly question at all. I’m actually so glad you asked because lots of people may be doing the same thing as you.
First of all, you should know that tendinitis is a condition that heals alone after a while. All you need to do is to rest. It’s a pretty common cause of joint pain in hands, but fortunately, it goes away on its own. So the fact that you took turmeric may have helped, but it only made it heal faster. Your tendinitis would have healed on its own anyway.
I don’t advise anyone to take turmeric for years unless they really have to. If you have an auto-immune condition that causes inflammation, then it’s necessary. But otherwise, don’t take it constantly. I’m not sure what you mean by “little breaks”, but in your case, you should have made a 1 month break ever 2 months.
But anyway, if tendinitis was the only reason why you took turmeric, I really advise you to stop. Tendinitis isn’t likely to come back, unless you exercise too intensively. And if you do, resting is the best treatment. Even so, there are very small chances that you ever get tendinitis again.
So please give up turmeric as soon as you can, because your kidneys and your gallbladder may get hurt at one point.
I’ve been taking tumeric 1MD for sometime
The last time I ordered they changed their ingredients ..now it is tumeric x285 with WokVel (boswella serrata) which is supposedly a faster delivery system. Now I’ve been getting daily nausea and dizziness for 3 months. Could it be this supplement? I just had an endoscopy done and have esophagitis.
Hey Jeanette.
Did you experience these symptoms right after starting the new version of this supplement? If these 2 periods coincide, your supplement may be the cause. Did you have any nausea while taking the initial turmeric supplement?
I know that Boswellia can cause certain side effects, so that’s why I’m asking.
Could you tell me the name of that supplement? That part with Boswellia increasing its the delivery of turmeric is pretty weird to me. I’ve been taking turmeric for years and I never heard that. So maybe I could dig into that supplement you’re using and see the truth about it.
I’ve just begun to take turmeric curcumin with ginger and have been experiencing heavy fatigue, Can this be because of the supplements? It’s really odd to me. I do eat turmeric rice and drink turmeric milk and also drink ginger tea. But when I take these supplements after eating I just feel like anywhere I am I want to lay down.
Hey Maritza, it could be because of the supplements. I never heard about this side effect before, but everyone is different, so it’s possible.
If this fatigue is too hard to bear, you can try to give up the supplement for a couple of days and see if it continues. If it goes away and then it comes back when you restart taking the pills, you might want to switch to another brand. This list could help you out.
Another thing you can try is to take the pills before eating. In fact, try to eat at least 30 minutes after taking them. I would normally not recommend that, because turmeric can produce nausea sometimes if it’s taken before the meal – but it depends from person to person. So you can try this and if the fatigue continues, then take the pills after meal, just as before.
Hope this helps. Get back to me in the future and let me know how it goes.
I have gout. It is new to me. I am on my first month of Allopurinol 199mg tab I also take blood pressure medicine. Taking the Allopurinol I still experence pain in my joints. So I got Turmeric Curcumin I take 1 Tablet with Breakfast and 1 Tablet with dinner. My pain has let up a lot. It says there is 450mg turmeric pwd., 50mg curcumin extract, Bottle is Nature Made. Am I taking to much?
Hi Sandra, I’m quite surprised to hear your joint pain got better from such a low dose of turmeric. What you’re taking is actually too little, in my opinion.
I know Nature Made’s supplement pretty well and I’m not its fan – because it has a very weak formula. Here’s what I mean:
1. It only contains 450 mg of turmeric powder. Most supplements contain over 1000 mg.
2. There are 50 mg curcumin extract and a good supplement would need about 100-1500 mg.
3. It has no bioperine, which increases the absorption of turmeric and curcumin. With bioperine, less than 50% of them gets absorbed. The rest is eliminated immediately. So you’re actually getting less than 200 mg of turmeric and under 25 mg of curcumin extract from these pills.
The only advantage I could find in Nature Made’s turmeric is price. There are very few supplements under $10, and this is one of them. But as I said, the price is proportional to the quality of this formula.
So I’m very surprised you had better results with this product than with Allopurinol.
But Sandra, if you had such good results with it, I wouldn’t switch to something else. As I said, it’s surely not the best turmeric supplement I know. But if it helps you and it’s still so cheap, continue using it. That’s what I would do.
can turmeric cause thrush in your mouth
Hi Kay, not really. Instead, it’s a pretty good remedy for that, so it surely didn’t cause it. Hope this helps.
my cyropracter just recomemded turmeric forte for joint and muscle pain but the side effects scare me,should i be worried and stop taking them today,im 78 and should realize that pain is a fact of life at my age
Hello Bernard. I didn’t really understand if you’re experiencing any side effect or you’re just scared that you might experience any in the future.
Well – if you’re already dealing with a side effect, maybe the brand isn’t well chosen. Some people react quite badly to certain turmeric brands but deal with no problems when switching to another brand. So if this is the first turmeric supplement you tired, my advice is to check out other options. Maybe another supplement won’t cause you any problem. Here’s a list of the best turmeric products I tried.
And don’t worry, you don’t have to pay a lot of money to get a good turmeric supplement. There are some that have a really low price and still work great (with rare side effects).
Now – in case you don’t have any side effect yet but you’re scared at the possibility that you might in the future, my advice is to forget about that.
I know this list sounds scary, but here’s the reality: less than 10% of people taking turmeric ever experience any side effect. Out of those 10% that do, more than 5% experience stomach pain or nausea, which are minor issues. And in most people, these symptoms go away after several weeks.
So that’s a general thing about side effects in any drug – they are a lot more rare than you think. NSAIDs also have lots of side effects but you rarely hear someone complaining about them. If people stopped using them just because there’s the chance to experience any side effect – believe me, most of us would be in pain very often.
And compared to NSAIDs, turmeric supplements’ side effects are a lot more rare and insignificant.
But if you want to make sure you won’t experience any side effect with turmeric, here’s my advice. Choose a product that has over 1000 mg turmeric powder and between 50 and 150 curcuminoides. Curcuminoides are curcumin extract, so I noticed that supplements with higher dosages (over 200) caused me side effects more often. That’s just my case, but it kind of makes sense, as the dosage is very high so it’s more powerful.
So I’m pretty sure that turmeric won’t cause you any problem, that’s why I advise you to give it a try as soon as you can.
I have a problem getting to sleep…doctor recommended Melatonin 10g and I have been quite successful with it. I am also using curcumin 95% but find now the Melatonin is not working anymore. Can you corroborate this side effect? Also have not experienced any relief from taking the max dosage of 2 per day with meals.
Hi Jeanne, this might be because the 2 drugs could interact with each other – so the effect of both decreases up to the point where you don’t feel any improvement. First of all, what kind of curcumin are you using (the name of the supplement)? Did Melatonin stop working after you added curcumin? If yes – try giving up curcumin for a while (1-2 weeks) and see if you can sleep better. Also, how long have you been taking the curcumin? In some people, it takes a few months until they see an effect – but it usually depends on the supplement.
Please answer these questions so that I can understand your problem better.
I have very annoying ringing in the ears. By taking turmeric, I believe it got worse. But it has helped the joint pains in my hands.
I am taking turmeric vegan capsules by Whole Foods, 2 capsules per day. Do you think this would cause the ringing to be worse?
Hi Eva. First of all – did the ringing appear only after you started using turmeric? Or you experienced it before at least once?
My advice is to reduce the dosage of turmeric from 2 pills to 1 per day. Pay attention to see if your joint pain stays as low as when you where taking 2 pills or if it increases. Also, see if your ringing gets better. If it doesn’t, try to stop taking those turmeric pills for a few days and see what happens.
If your ringing disappears, it’s probably because of turmeric. But you should switch to another brand and see if the ringing returns. It might be something in Whole Food’s product or it might be something that your body doesn’t like about turmeric, and that’s why you have this reaction. But anyway, ringing isn’t a common side effect of turmeric – I personally never heard it before. That’s why it could be the brand.
So please follow this advice and let me know what happens.
I took 1 500 mg capsule and broke out in a bad rash on my back and legs.
Hi Christine, sorry about your issue. But 1500 mg isn’t a very high dosage. Actually, I recommend between 1000-1500 mg per day, so you’re in the good limits. Is this the first brand you’re trying or you also used another one? I’m trying to figure out whether it’s something specific about turmeric in general or if it could be because of additives/extra ingredients.
You could also try to reduce the dosage to half (take 1 pill if the label recommends 2 and so on) and see what happens.
Please get back to me with more details so that I can give you a more detailed answer.
Just doing some checking on averse effects with Cumin and Turmeric as I never really felt it worked for me any maybe making my inflammation worse. It became apparent to me due to body pain and headaches that I was allergic to Cumin, so I stopped cooking with it. But then started having severe rashes on my fingers, hands and wrists, really bad headaches, ear aches, dry cracking skin, itching skin, led to being really sick, mostly upper respretory breathing, vision, hearing, etc. I finally realized it was Turmeric W/ Ginger capsules! Just don’t want any one else to ever have to experience this!
Hi Linda, I’m so sorry to hear about your issues. You’re probably one of those few people that are really allergic to turmeric/curcumin (not just partially). So in your case, it’s probably best to avoid this herb completely.
That’s a shame, because turmeric is the best herb for inflammatory pain of all. But luckily, there are some other ones that can help. So I advise you to check out the options you have and start using supplements/products based on those. I really hope this helps you.
Hi am new at the turmeric product. I have been taking some turmeric supplements for about 2 weeks. Can it cause yeast infection?
Hi Lus. Turmeric alone doesn’t really cause yeast infection, nor it increases the risk. So I don’t really think it’s because of this herb. Could you tell me what exact supplement you’re taking (the brand)? It might contain additional ingredients that could be connected to a higher risk of yeast infection, though I king of doubt it. But everything is possible, so it would help me knowing the brand.
What can I do to prevent explosive diarrhea when I take Turmeric?
Hi Phyllis. There’s no certain way to prevent it because it’s a side effect. You can’t prevent the fact that your body doesn’t tolerate a certain food – so it’s the same with turmeric. But what you can do is to try a different brand (if we’re talking about a supplement) or a different supplier (if we’re talking about organic powder).
For instance – in case you’re taking a supplement:
1. Check out its ingredient list and see if it only contains turmeric powder (like Spring Valley’s product), if there’s also bioperine (like Turmeric Plus) or if it’s a product with a superior absorption (like Smarter Nutrition’s product).
2. Depending on that, give up that supplement and go for another one with a different composition.
3. Try to take it after eating, in order to prevent stomach cramps (these can be prevented by not taking the pills on an empty stomach).
But there’s no actual way to prevent this, because it’s a side effect that only appears in some people. You’re probably unlucky to have it, just like others are unlucky to get diarrhea from aspirin or any other drug. I hope this helps any little bit.
I have been on this for 6 weeks,it has helped a lot but I am itching so much but more worrisome is the weird cramps I am having in my sides,, upper arms jaw and stomache .Places I didn’t realize you could have them. It has been a miracle for me,I have lupus and arthritis.I don’t want to stop them but need to know if this is what is causing these symptoms.I take NATURES NUTRITION,1950 mg 3*a day of TURMERIC CURCUMIN with BIOPERINE.
Hi Beverly, thanks for your feedback on turmeric. If the symptoms and the itching worsened only after you started using these pills, it’s most likely they are responsible. But the good news is that you could see an improvement from turmeric, which means it’s helpful.
Normally, side effects to turmeric appear when you’re taking a dosage that is too high for your body. 1950 mg is a high dosage, so I would suggest the following:
– Either take 2 pills instead of one from this supplement, as this will reduce the daily dosage.
– Or try another supplement with a lower overall dosage (somewhere around 1200-1500 mg per day is the best quantity, from what I noticed). If you need some recommendations, here are my top picks.
Follow one of these 2 tips and see whether your itching and cramps decrease, but also if your relief remains the same. And please let me know so that I can give you further advice if needed. I hope this helps you.
Hi I just started Turmeric 500mg with 5mg black pepper 2x a day for approximately 2 weeks. I have an issue with reflux disease.
I have been diagnosed with onset arthritis in my hips and neck. I’m a 62 1/2 year young mail in good health.
Is there a better way to absorb Turmeric or a lower dose? I was taking it after breakfast and after dinner. I felt it was helping. When I stopped approximately a week ago my issue in my esophagus went away. I want to take advantage of the benefits if possible.
However is there an alternative solution? Chondrotine, MSM etc. etc. Would the ginger make a difference?
Thank you Jack in Staten Island NY 🙂
Hi Jack, I’m really sorry to hear about your issues.
Acid reflux is a pretty common side effect of turmeric but it’s usually related to the herb itself, not to absorption boosters or additional ingredients. That’s why I doubt a formulation without bioperine would help more, because it’s still based on turmeric. However, you can give it a shot. Among turmeric supplements with a superior formula that doesn’t contain bioperine, I would recommend Smarter Curcumin or Curamed’s Curcumin. They both have strong formulas but a pretty high price as well. So you should only give them a try if you afford them on the long term (3-4 months).
Now – the 500 mg of turmeric you’re taking now is a pretty low dosage. I normally recommend supplements that have around 1000-1500 mg per serving. So if you got this side effect with such a little dose, I doubt one of the products I normally recommend (with higher doses) would be more helpful. Once the dose of turmeric increases, so does its risk of side effects.
So for now, I would probably try a non-bioperine formulation if I were you. I’m not very sure it’s going to prevent your acid reflux, but you need to try if you really want to find it out.
I would also need to know what kind of joint problem you have. Is it osteoarthritis? Is it cartilage damage? I usually recommend glucosamine + chondroitine products in these cases, as supplements based on them are the best when it comes to repairing damaged cartilages. On the other hand, turmeric decreases inflammation – which is more common in joint problems caused by rheumatoid/psoriatic arthritis or chronic pain. So could you give me more details about your condition and whether you have a diagnosis or not? That would be really helpful.
Hello I just tried golden turmeric milk today hoping it would help with the inflammation pain in my neck and low back due to arthritis and fibromyalgia. Before I drank the golden milk my pain level was a 6. An hour after the pain was gone. I used 1 cup almond milk, 1/2 tsp organic turmeric, 1/2 tsp coconut oil, 1 tsp. honey. How delicious!! So I need to know if turmeric can cause insomnia. I found some sites say yes, some say no so I’m confused. It is so delicious I’m actually craving it! Thanks for any info. Bless you
Hello there, thanks a lot for your feedback.
I’m so happy to hear you saw such an improvement in your pain with turmeric golden milk. One hour is very fast and the fact that your pain decreased from 6 to 0 is some excellent news. So all I can tell you is to continue using golden milk and hopefully it has the same positive results. In some cases, the body gets used to it and the pain stops decreasing so much, but I really hope that’s not your case. Still, if something of this kind happens, just let me know and I will try to help.
Regarding your questions, turmeric can cause a bunch of side effects and they all depend from person to person. But insomnia is far from a common side effect of turmeric, so I wouldn’t worry to much about it. That especially since you’re taking turmeric milk, which doesn’t have a very high dose (compared to supplements).
Now, it’s true that turmeric causes different side effects and it all depends from person to person. But these 9 secondary reactions listed in my article are by far the most common. And as you can see, insomnia isn’t on this list, so it’s quite rare. That’s why there are very low chances that you develop it, to be honest. You should worry about the most common side effects (like stomach pain and nausea) instead. But considering that you’re getting a low dose of turmeric, I pretty much think you will be free from those side effects.
I really hope this helps you!
Dear Heather
There is another complication with curcumin – it acts as a broad spectrum antibiotic (this may be why some people exhibit gastrointestinal discomfort).
It is also why it can be quite dangerous for people taking digoxin. Aproximately 10% of the population have a strain of Eggerthella lenta in their gut which can break down digoxin. Curcumin (and some other antibiotics) can kill these bacteria, allowing the concentration of digoxin to increase in the blood. Because of its narrow theraputic index this may lead to digoxin intoxication which may be fatal.
Hi Mitchell, what you’re saying is completely true. Turmeric is one of the few herbs that can interact with certain drugs – and therefore it’s not allowed to be combined with them. The most common categories are blood-thinners and high-blood pressure drugs. Digoxin is also a heart medicine but it’s not meant only for high-blood pressure. Anyway, the problem with digoxin is that it has a very low therapeutic ratio. This means the difference between its therapeutic dose ad lethal dose is very low. That makes it a very dangerous drug and that’s why it’s not recommended to be combined with anything (unless if the doctor recommends so).
So for people taking digoxin or its derivatives, asking the specialist before taking turmeric is a must.
Do you know how long does turmeric capsule work for arthritis? I’m taking 1 gm a day with mild nausea and burping bec of my GERD. Should I still take it since not feeling any better yet after taking for a week.
Hi there, it usually takes at least a month for a real improvement to appear. So yes, I say you should stick to turmeric for a couple of weeks more. However, if you’re experiencing these side effects, you might want to try a different supplement. In this way, you can see if your body gets these secondary reactions to turmeric itself or only to that product you’re taking at this point. That should help you clarify the issue.
Hi Heather I have Gord and a Chronic cough my specialist told me to take Curcumin for a joint damage and have to have a knee replacement.He also said to take Fish Oil and Glucosomine and Vitamin D. My cough has got worse to the extent it is causing my life to be miserable. I take indapamide for blood pressure . Could it be the Curcumin its not the Idapamide as I have taken it for years. thank you in advance Linda
Hi Linda, sorry to hear about your issues. Curcumin and turmeric-based supplements can interact with blood pressure medication, so I don’t recommend taking them together (unless you have your doctor’s consent). However, curcumin products are mostly designed for inflammation, which is only a consequence of joint damage (not the cause). The actual cause is cartilage tear and it’s actually glucosamine + chondroitin that works best in this case (they can rebuild damaged cartilages while curcumin can’t do that, it only reduces consequent inflammation). Plus, glucosamine and chondroitin don’t interact with blood pressure medication, so you can take a glucosamine-based products while taking your current medication. You should also ask your doctor, though, but the risk of interactions is very low (compared to that of curcumin products).
Here are my top recommended glucosamine + chondroitin supplements in terms of quality/price, in case you need some suggestions. Hope this helps!
I appear to have an increased sweet tooth and gaining weight I have been taking turmeric for 3 weeks and don’t appear to have and relief from painful knee joint it natural garden 400mgs twice day
Hey Margaret. Do you think it’s the turmeric that made you gain this weight or it’s simply a coincidence? I just checked the product you mentioned and it’s not one I would normally recommend. It contains 800 mg of turmeric per serving (so per 2 capsules), but it doesn’t have any curcumin (turmeric extract) or curcuminoides (an even more concentrated extract). Not to mention that it also doesn’t have any BioPerine (which is essential for absorption, because turmeric isn’t absorbed too well by the human body naturally). Normally, I recommend a supplement that contains about 1000-1500 mg turmeric, 100-150 mg of curcuminoides and 10-15 mg of BioPerine. So the product you’re taking doesn’t really fit into these standards, and that’s mostly because its doses are much lower so its overall effect is weaker.
In case you need some recommendations (for a really good price), you can check out my top picks.
Hope this helps.
I have found that fresh turmeric has less side effects. Powders have caused indigestion so when I do use it I buy organic powders from the spice rack. With the fresh I make paste and use it in my daily fruit and vegetable shake. The only thing I have found is that to much will cause some of the side effects that have been posted. Thanks.
Hi Greg, thanks for the feedback on turmeric, I never really thought that powdered turmeric could be more dangerous than fresh one (in terms of side effects), but that’s totally possible. It could also be only in your case, but I can’t tell for sure. Thanks again for sharing your experience!
Rexall from Dollar General turmeric Curcumin 500mg is what my mom gave to me as she’s on like a million different pills and the research that she did led her to get rid of it. I told her that I would try it for myself for multiple reasons but worried that my iron would drop too low so I took one pill and I’ll await your response.
Hi Monica, I cannot tell you for sure what is going to happen. Side effects don’t appear in everyone – and some people can experience a certain side effect, while others can experience another one (or none). That’s why I advise you to take the product for several weeks and see what happens. You could also have some blood tests in that time and check your iron levels.
But don’t worry – if this product really makes your iron levels drop, giving it up should stabilize them. So it’s not an irreversible side effect. Hope this helps!
I have never had problems with turmeric before, but tried curcumin with Bioperine. I developed insane itching in my hands and pretty sure it’s from that and discontinuing. Benadryl and hydrocortisone cream did nothing for relief. Oddly, the most temporary relief is from running very hot water over them instead of cold. If I don’t get permanent relief in a few days I will see doctor. Side note: I am treating for a rare cancer Angiosarcoma that developed 5 years later from the radiation treatment following a lumpectomy of breast cancer. I am “between” chemo treatment right now as I had to have another surgery for more tumors after the mastectomy, so whatever the hand itching is from, it’s not from interaction with chemo.
Hey Diane, I’m so sorry to hear about your health problems, I really wish you the best for the future! There are some people who are allergic to BioPerine, so they can’t take the combination between turmeric/curcumin and BioPerine. That’s such a shame, because turmeric really needs this compound in order to absorb properly. So the only option you have is to go for a product that contains a form of turmeric/curcumin that is specially formulated for a faster absorption. This kind of products tend to be a lot pricier, that’s why I don’t usually recommend them (even though they work really well). So one product that I can recommend you is CurcuminMD, which actually has a really affordable price for that kind of supplements and it doesn’t have any BioPerine (it’s formulated for a faster absorption).
Hope this helps you!